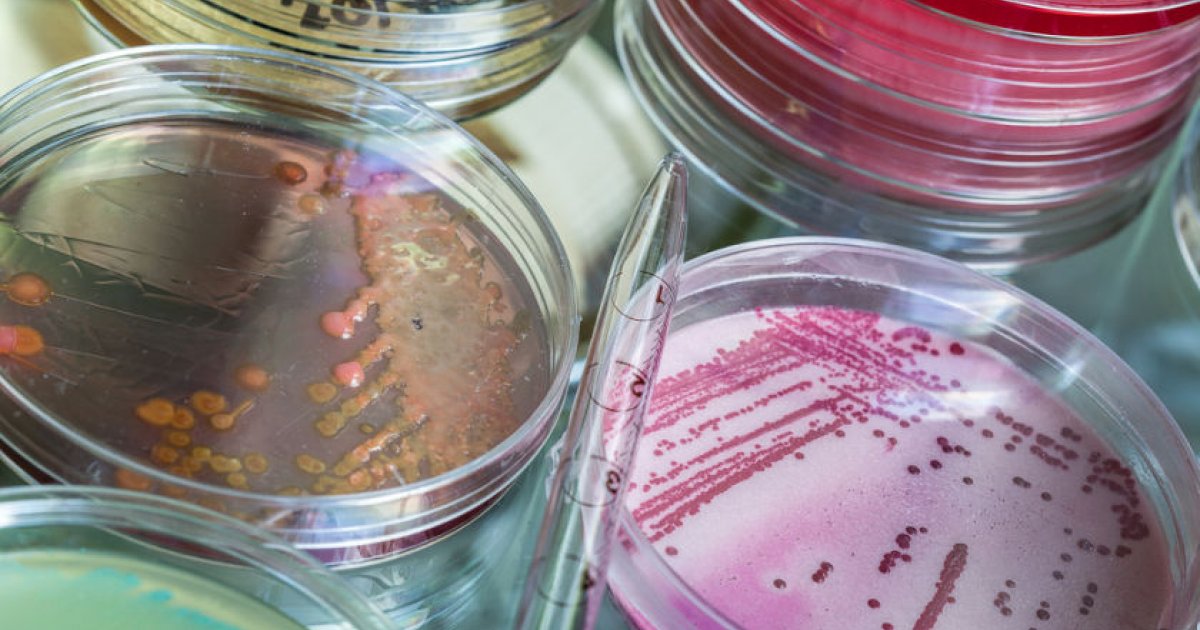

Risk Factors Associated With A Vitamin B12 Deficiency
Vitamin B12 deficiency is a condition in which a patient does not have enough vitamin B12 in their blood. Even a mild deficiency in vitamin B12 affects an individual's quality of life, causing fatigue and mental fog. A more severe deficiency can lead to problems with heart and brain function. Some causes of vitamin B12 deficiencies are dietary, in which case the problem is easily solved through supplementation or a diet plan. Other causes are more insidious and include things like autoimmune diseases and parasitic infections. Usually, medical conditions that cause vitamin B12 deficiency involve problems with absorbing nutrients properly. Get to know what can increase an individual's risk of a vitamin B12 deficiency now.
Graves' Disease

Graves' disease is an autoimmune disease in which the immune system attacks the thyroid gland. It causes hyperthyroidism, which negatively affects virtually every organ system in the body. This illness can deplete the body of many vitamins and minerals, including vitamin B12, by causing the organs to use up nutrients faster than they should. Autoimmune diseases, in general, are associated with a vitamin B12 deficiency. This disease is just one of many autoimmune diseases; others include lupus, ulcerative colitis, and Crohn's disease. If a patient has one autoimmune disease, they also have an increased risk of developing another autoimmune disease in the future. This heightens the risk of a vitamin B12 deficiency even more.
Keep reading to learn about the next risk factor for a deficiency in vitamin B12.
Celiac Disease

Like Graves' disease, celiac disease is an autoimmune disease associated with vitamin B12 deficiency. When this illness is left untreated, it causes damage to the intestinal lining, and when the intestines are damaged, they cannot absorb a normal amount of nutrients. Thus, someone who suffers from celiac disease is likely to have a host of deficiencies, including one in vitamin B12. Celiac disease is treated by having the patient follow a strict diet with no gluten. If the patient is compliant with this, the intestines should heal and be able to absorb nutrients normally again. Many patients stop being deficient in vitamin B12 after beginning to follow a gluten-free diet. However, if a patient has many symptoms of vitamin B12 deficiency or if their deficiency is considered severe, the doctor may recommend taking supplements.
Learn more about what may result in a deficiency of vitamin B12 now.
Atrophic Gastritis

Atrophic gastritis is yet another autoimmune disease associated with vitamin deficiencies, particularly of vitamin B12. It involves the immune system attacking the mucous membrane of the stomach, leading to inflammation and a lack of digestive fluids and enzymes. The stomach then cannot fully digest food. One of the substances the stomach is unable to make enough of in atrophic gastritis is a protein called intrinsic factor. In a normally functioning stomach, this protein is essential for the ability to absorb vitamin B12. Therefore, vitamin B12 deficiency is a common problem for patients who suffer from atrophic gastritis. Symptoms of vitamin B12 deficiency may even be among the first symptoms of atrophic gastritis. Injections of vitamin B12 are sometimes used as treatment.
Get familiar with the next risk factor for a vitamin B12 deficiency.
Pernicious Anemia

Pernicious anemia is a type of anemia that occurs when the body does not have enough vitamin B12 to make the right number of red blood cells. The loss of red blood cells can cause serious heart problems and neurological problems over time, including permanent nerve damage and heart enlargement. Pernicious anemia is usually treated with injections of vitamin B12; supplements are sometimes an option depending on how severe the condition is. Pernicious anemia often occurs alongside other diseases, such as autoimmune conditions. Sometimes another disease directly causes it. If this is the case, additional treatments are often necessary along with the vitamin B12 injections to make sure pernicious anemia does not recur.
Discover more vitamin B12 deficiency risk factors now.
Bacterial Growths Or Parasites
Sometimes bacterial growths or parasites may lead to a deficiency in vitamin B12. In the developed world, this is a less common cause of a vitamin B12 deficiency, but it is a possibility. An overgrowth of certain types of bacteria in the gut can prevent vitamin B12 from being absorbed from food. Normal, healthy intestines contain a whole ecosystem of bacteria that help humans digest their food. However, sometimes the intestines become infected with a bacterial species that is not supposed to be there. The unwelcome bacteria can start to take over and interfere with digestion and nutrient absorption. This leads to deficiencies in several vitamins including vitamin B12. Parasites like tapeworm and giardiasis can also interfere with nutrient absorption and cause a vitamin B12 deficiency. These parasites steal nutrients from their hosts and cause all kinds of deficiencies and malnutrition. Individuals can become infected when they eat or drink contaminated food or beverages.